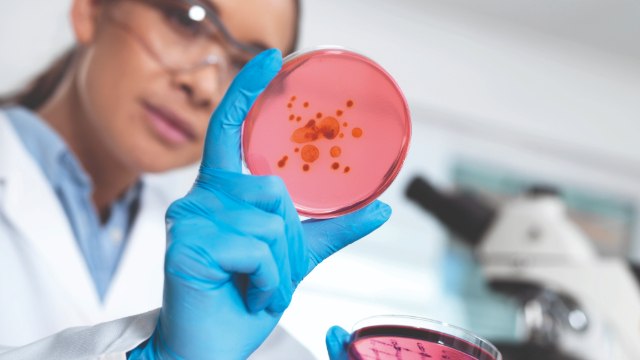
<p>Guidance to ISO 11133 Compliance: Water Sourcing for Microbiology Culture Media</p>
Scientist holding petri dish

Water for Cell & Molecular Biology

Water purity is crucial in cell biology and molecular techniques as contaminants can significantly affect experimental outcomes and reproducibility. In cell culture, impurities can disrupt cell growth and function. In protein research, water quality may impact protein structure and affect enzymatic activity. Water impurities may also affect the quality of protein analysis or purification. Nucleases are often present in water and may degrade DNA or RNA samples and lead to false results in PCR and other genomic research techniques.
Understanding the impact of specific water contaminants on these sensitive techniques is critical to ensure experimental reliability and consistency. Below you will find products and information to support you in selecting the optimal water quality for your sensitive biological applications.
Featured Categories
Milli-Q® systems offer innovative water purification technologies engineered to support lab research needs, sustainability goals, and other major requirements.
From a single lab to an entire building, Milli-Q® central water purification systems are connected, high-performance instruments that can reliably feed all purified water needs.
Find the cartridges, UV lamps, filters and polishers for your water system. Advantages of using genuine Milli-Q consumables: guarantee water quality, sustainability features (new Drain Cap, Hg-free lamps). Designed for perfect fit.
Milli-Q® water system accessories support lab-specific needs, improving safety, water quality, and productivity while conserving bench space.
Impact of Water Quality on Cell Culture
As water is the largest component in any culture media formulation, its quality is critical for reliable and reproducible methods. Correct water quality is important when preparing cell culture media as impurities can affect media performance or cause abnormalities, such as changes in pH or color, or cause precipitates. Water should be free from substances, such as bacteria, heavy metals, endocrine disrupters, and endotoxins (pyrogens), which can effect cell growth and function. Using ultrapure water purified by ultrafiltration ensures the removal of these contaminants and supports the integrity and reproducibility of cell culture experiments.
Impact of Water Quality on Protein Research
High-purity water is crucial in protein research and proteomic studies. Water impurities can affect protein folding, stability and activity. Using optimal water purity is also essential for techniques like ELISA, Western blotting and protein purification techniques, where contaminants can compromise accuracy and lead to erroneous conclusions.
Impact of Water Quality on Genomics Research
The inherent sensitivity and specificity of many genomic techniques, such as PCR and sequencing, demands very high purity reagents. Nucleases, even in trace quantities, can degrade DNA and RNA samples, impacting processes like nucleic acid extraction, PCR, gene editing or sequencing. Organic contaminants (e.g. humic acid, polysaccharides) may mimic the structure of nucleic acids or interact with them, while inorganic contaminants, like some metals, can interact with polymerases and reverse transcriptase, compromising the results of PCR-based techniques. These sensitive techniques require the use of nuclease-free ultrapure water to prevent degradation of DNA/RNA and to maintain results reliability and consistency.
Visit our document search for data sheets, certificates and technical documentation.
Related Articles
- Technical article on Selecting the Right Water Purification System
- Next-generation sequencing (NGS) revolutionized genomic research, and is now playing a crucial role in the clinical environment.
- See All (0)
Find More Articles and Protocols
How Can We Help
In case of any questions, please submit a customer support request
or talk to our customer service team:
Email custserv@sial.com
or call +1 (800) 244-1173
Additional Support
- Lab Water Solutions Support
Receive professional assistance in identifying the optimal water solution for your laboratory.
- Calculators & Apps
Web Toolbox - science research tools and resources for analytical chemistry, life science, chemical synthesis and materials science.
- Customer Support Request
Customer support including help with orders, products, accounts, and website technical issues.
- FAQ
Explore our Frequently Asked Questions for answers to commonly asked questions about our products and services.
To continue reading please sign in or create an account.
Don't Have An Account?